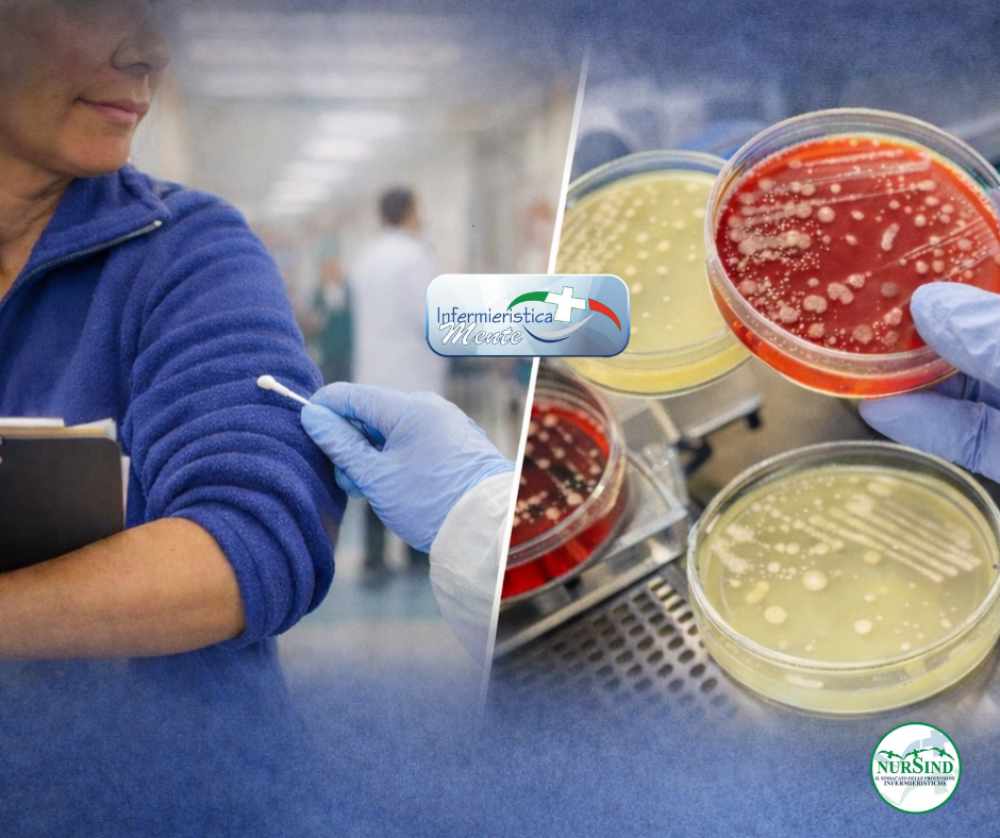

Camici e pile sotto accusa. I rischi delle maniche lunghe in corsia di infermieri e medici
Uno studio condotto in un grande ospedale statunitense riapre il dibattito sulla politica “bare below the elbows” e sull’uso di indumenti a maniche lunghe durante l’assistenza ai pazienti.
Le maniche lunghe degli operatori sanitari sono spesso contaminate da batteri e, in un caso su cinque, ospitano microrganismi potenzialmente patogeni. È quanto emerge da un nuovo studio osservazionale prospettico pubblicato sulla rivista Infection Control & Hospital Epidemiology, che analizza in modo sistematico un tema da anni al centro del dibattito sulla prevenzione delle infezioni ospedaliere.
La ricerca è stata condotta in un ospedale universitario di terzo livello da 900 posti letto negli Stati Uniti, con l’obiettivo di stimare la frequenza della contaminazione batterica degli indumenti a maniche lunghe indossati dal personale sanitario e di capire quali fattori possano favorirla.
Uno studio sul campo, tra corsie e reparti
Tra aprile e ottobre 2024, 280 operatori sanitari impegnati nell’assistenza diretta ai pazienti ricoverati – infermieri, medici, operatori sociosanitari, terapisti e altri professionisti – hanno accettato di partecipare allo studio. Tutti indossavano abiti a maniche lunghe durante il turno di lavoro.
I ricercatori hanno prelevato campioni microbiologici da entrambe le maniche, concentrandosi sui polsini, l’area considerata più a rischio di contaminazione. I tamponi sono stati poi coltivati in laboratorio per individuare la crescita di batteri aerobi o facoltativi, distinguendo tra flora cutanea normalmente innocua e potenziali patogeni.
Parallelamente, i partecipanti hanno compilato un breve questionario su ruolo professionale, tipo di indumento, materiale, frequenza di lavaggio, adesione alle precauzioni standard e alle pratiche “bare below the elbows” (letteralmente “avambracci scoperti”), che prevedono l’assenza di maniche lunghe, orologi e bracciali durante l’assistenza.
I risultati: contaminazione diffusa, pile più a rischio
I numeri parlano chiaro. Nell’81,1% dei campioni analizzati è stata riscontrata una crescita batterica. Nel 20,7% dei casi è stato isolato almeno un potenziale patogeno.
Tra i microrganismi identificati figurano streptococchi alfa-emolitici, specie di Bacillus, batteri gram-negativi come Pantoea e Acinetobacter, e, in alcuni casi, Staphylococcus aureus, noto per il suo ruolo nelle infezioni ospedaliere.
Un dato particolarmente rilevante riguarda il tipo di indumento. Le giacche in pile, sempre più diffuse nei reparti al posto del classico camice bianco, sono risultate significativamente più contaminate rispetto ad altri capi come camicie a maniche lunghe, giacche eleganti o camici. Anche il materiale ha fatto la differenza: i tessuti sintetici, in particolare il pile, hanno mostrato una maggiore probabilità di ospitare patogeni rispetto al cotone o a materiali misti.
Secondo gli autori, ciò potrebbe essere legato alle caratteristiche delle fibre sintetiche, che favoriscono l’adesione dei batteri e la formazione di biofilm più resistenti al normale lavaggio domestico.
Terapia intensiva e reparti ordinari: una differenza inattesa
Un altro risultato interessante riguarda il contesto assistenziale. Le maniche campionate nei reparti non intensivi hanno mostrato una probabilità maggiore di contaminazione batterica rispetto a quelle delle terapie intensive. Una differenza che gli autori interpretano con cautela, ma che potrebbe riflettere una maggiore attenzione alle misure di controllo delle infezioni negli ambienti a più alta intensità di cura.
Al contrario, fattori come il ruolo professionale, il tempo trascorso dall’ultimo contatto con il paziente, la durata del turno o l’intervallo dall’ultimo lavaggio dell’indumento non sono risultati significativamente associati alla contaminazione.
Nessuna prova di trasmissione ai pazienti
Uno degli aspetti più innovativi dello studio è l’uso del sequenziamento dell’intero genoma (WGS) per confrontare i batteri isolati dalle maniche con quelli raccolti dai pazienti nell’ambito della sorveglianza microbiologica ospedaliera.
Il confronto non ha mostrato alcuna correlazione genetica tra i ceppi presenti sugli indumenti del personale e quelli responsabili di infezioni cliniche nei pazienti. In altre parole, pur in presenza di una contaminazione frequente, lo studio non ha documentato eventi di trasmissione diretta.
Un risultato che invita alla prudenza nelle conclusioni: la contaminazione esiste, ma il suo reale impatto sulle infezioni ospedaliere resta da dimostrare.
Il ritorno del dibattito “bare below the elbows”
Nel Regno Unito, la politica “bare below the elbows” è in vigore da quasi vent’anni ed è sostenuta da linee guida di esperti, tra cui la Society for Healthcare Epidemiology of America. Negli Stati Uniti, però, non è obbligatoria e le politiche sull’abbigliamento variano da ospedale a ospedale.
Questo studio non fornisce prove definitive a favore o contro l’adozione di tale politica, ma suggerisce che il cambiamento delle abitudini di abbigliamento – in particolare l’uso crescente di pile e giacche sintetiche – potrebbe avere implicazioni sulla trasmissibilità batterica.
Gli autori sottolineano che eventuali raccomandazioni non dovrebbero limitarsi al camice bianco, ormai poco utilizzato, ma considerare tutti i capi a maniche lunghe indossati quotidianamente in corsia.
Limiti e prospettive future
Come ogni studio, anche questo presenta dei limiti: è stato condotto in un singolo ospedale, non ha incluso il personale del pronto soccorso e si è concentrato solo su batteri aerobi, escludendo patogeni come Clostridioides difficile. Inoltre, alcune informazioni, come la frequenza di lavaggio degli indumenti, erano basate su autodichiarazioni.
Nonostante ciò, il lavoro fornisce dati solidi e attuali su un tema spesso discusso ma poco esplorato con strumenti avanzati come il sequenziamento genomico.
Le maniche lunghe degli operatori sanitari risultano frequentemente contaminate da batteri, inclusi potenziali patogeni, soprattutto quando realizzate in pile o materiali sintetici. Al momento, però, non emergono prove di una trasmissione diretta ai pazienti. Il messaggio finale è di cautela: prima di imporre o escludere politiche come il “bare below the elbows”, servono ulteriori studi, capaci di collegare in modo chiaro l’abbigliamento del personale agli esiti clinici dei pazienti.
da: Sanes Guevara MF, Barry MC, Clemons NC, et al. Healthcare worker long-sleeved attire contamination: a prospective observational study. Infection Control & Hospital Epidemiology. Published online 2025:1-7. doi:10.1017/ice.2025.10378

di
di